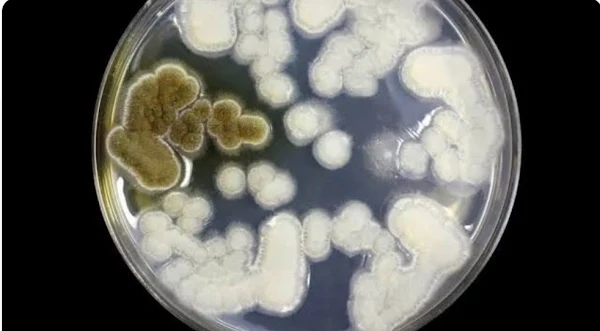

Por Augusto Dala Costa Editado por Luciana Zaramela
Cientistas alertam que a próxima pandemia poderá ser causada por fungos, e não por vírus, segundo reporte da National Geographic. Além de sabermos menos do que gostaríamos sobre essas criaturas, eles têm uma grande resistência a tratamentos, o que dificultaria medidas de contenção caso uma epidemia de infecções saísse do controle.
Epidemiologistas do CDC (Centers for Disease Control and Prevention, agência de saúde estadunidense), por exemplo, relatam o grande potencial causador de doenças que os fungos têm. Eles evoluem em taxas extremamente rápidas e viram infecções cada vez mais difíceis de se tratar com anti-fúngicos, já que os remédios que os afetam geralmente fazem mal a nós, humanos, também.
Além disso, os fungos podem forçar o sistema imune a se virar contra si mesmo, uma condição potencialmente fatal chamada sepse. Em casos mais graves, os fungos podem até mesmo formar bolas dentro do corpo que deslocam órgãos inteiros. Em relação às taxas de mortalidade, elas subiram em 25% com patógenos resistentes a medicamentos anti-fúngicos.
![]() |
| Com espécies muito variadas, os fungos podem ser benéficos ou maléficos para nós, e precisamos estar preparados (Imagem: twenty20photos/envato) |
Perigos evolutivos.
O uso de fungicidas na agricultura, por exemplo, permite que fungos resistentes evoluam para ter uma resistência maior ainda, desenvolvendo imunidades muito perigosas. Embora evoluam mais devagar do que bactérias ou vírus, os fungos podem se adaptar e reproduzir em grande variedade de ambientes. Caso comecem a se espalhar rapidamente entre os humanos, isso pode ter consequências sérias.
A resistência a um fungicida pode se desenvolver em uma pessoa, e a resistência a outro fungicida, em outra. Essa resistência pode acabar combinada pela reprodução sexuada dos fungos em questão, gerando um descendente ultrarresistente e muito mais perigoso. As mudanças climáticas também podem ajudar a piorar o quadro ao deixar as temperaturas mais convidativas para os potenciais patógenos.
Em resumo, os fungos têm conseguido conquistar um lugar na lista de ameaças potenciais quando o assunto são surtos de doenças em humanos. Especialistas estão, no momento, trabalhando no desenvolvimento de vacinas fúngicas, algumas já sendo testadas em laboratório. Enquanto os fungos estão praticamente onipresentes e, em muitos casos, são até benéficos para nós, as condições certas podem torná-los uma ameaça para nós — e é bom que estejamos preparados quando ela vier.
Fonte: National Geographic Reports
Tags
SAÚDE